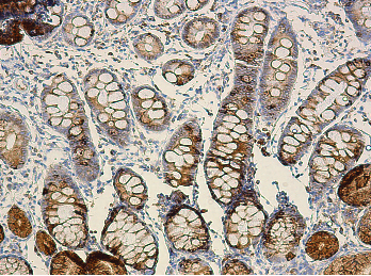

Our Vision
We are dedicated to decipher the role of genetic diseases in our patients. Our projects focus on the identification, characterization and functional analyses of novel human disease-causing genes in order to elucidate the disease pathophysiology and potentially provide targets for personalized medicine. of rare monogenic disorders Our Research Laboratory aims to discover novel disease-causing genes and investigate the pathophysiological mechanisms of rare monogenic phenotypes in families referred to the Genetics Institute at Tel Aviv Sourasky Medical Center or by colleagues. We use in-house next generation sequencing and bioinformatic analyses for deciphering the genetic causes of rare diseases, and functional assays are tailored to accommodate each novel disease-causing gene, pathway and phenotype. in a candidate gene on inflammatory response pathways in atopic diseases, intestinal permeability and protein losing enteropathy We identified a rare variant suspected to cause protein-losing enteropathy, food allergies and eosinophilic disease in a homozygous state, while conferring susceptibility to atopic disease in heterozygous carriers. We are studying the pathways involved and the effects of this variant on disease states. for Yellow Nail syndrome (YNS) YNS is an ultra-rare disorder characterized by yellow dystrophic nails, bronchoectasias and lymphedema. We identified bi-allelic variants in several YNS patients. This gene is associated with planar cell polarity pathway, and we are investigating its role in lymphatic abnormalities and other YNS manifestations. and diabetes-related gene in disease pathophysiology We are studying the role of a novel poorly-characterized gene in pathways related to obesity and glucose metabolism, and how specific mutations in this gene cause obesity and diabetes in patients. and cardiovascular disease We are studying the effects of a complete loss of a gene in the natriuretic peptide pathway in a family with hypertension, arrhythmia and atrial fibrosis of intronic variants The genomic era brings to light many variants in intronic and regulatory regions, the effect of which is often difficult to predict. Part of our research efforts aims to characterize the consequences of candidate variants in such regions, and to learn more about their effects on gene expression and function From The Press
Highlight Publications
Our Team
Research
Specific examples for projects are listed below

Translational Genetics
and Genomics Research Laboratory